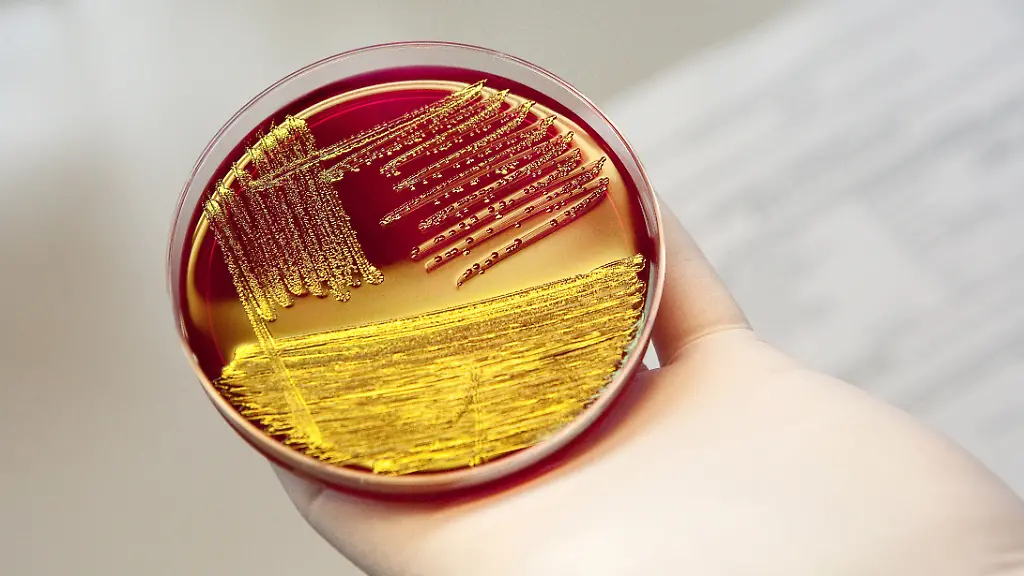
99666132

RKI beobachtet die LageMehrere Tote durch Ehec-Infektionen in Belgien
In Belgien sterben durch Ehec-Infektionen fünf Menschen. Auch in Deutschland liegen mehrere Kinder mit dieser Erkrankung auf der Intensivstation. Das RKI erklärt, die Lage genau zu beobachten.
In mehreren belgischen Seniorenheimen sind etwa 20 Menschen an Ehec erkrankt. Die flämische Behörde für Pflege und Gesundheit bestätigte den Tod von mindestens vier Personen. Es wird vermutet, dass sich die Betroffenen über kontaminiertes Essen mit dem toxinbildenden Bakterium ansteckten. Lebensmittel wie rohes Fleisch, roher Fisch, Rohkost oder Rohmilch könnten die Quelle einer solchen Kontamination sein, teilte eine Sprecherin der belgischen Agentur für die Sicherheit der Nahrungsmittelkette (Agence fédérale pour la sécurité de la chaîne alimentaire - AFSCA) mit. Die ersten Krankheitsfälle seien in der vergangenen Woche aufgetreten. Seit Mittwoch berichten belgische Medien von Todesfällen.
Laboranalysen zeigten, dass die Infektionen durch denselben Typ des Ehec-Bakteriums verursacht wurden, was auf eine gemeinsame Quelle für diese Infektionen hindeutet, wie es in einer gemeinsamen Mitteilung der AFSCA und der flämischen Gesundheitsbehörde hieß.
Auch in Deutschland ist die Situation unter genauer Beobachtung. Nach mehreren schweren Ehec-Infektionen bei Kindern und Erwachsenen in Mecklenburg-Vorpommern sieht das Robert Koch-Institut (RKI) aktuell aber keine Hinweise auf eine Häufung von Ehec-Fällen in anderen Regionen Deutschlands. Gleiches gelte für das sogenannte hämolytisch-urämische Syndrom (HUS), sagte eine Sprecherin.
Mehrere Fälle in Mecklenburg-Vorpommern
Das RKI beobachte die Situation aber weiter sehr genau. Ein Expertenteam aus dem Bereich der Infektionsepidemiologie stehe in engem Kontakt mit den lokalen Gesundheitsbehörden, erklärte die Sprecherin.
In Rostock in Mecklenburg-Vorpommern sind nach jetzigem Stand zehn Kinder und Jugendliche im Alter zwischen 1 und 15 Jahren sowie zwei Erwachsene an Ehec erkrankt. Fünf weisen nach Angaben des Landesamts für Gesundheit und Soziales ein HUS auf, das ein Nierenversagen zur Folge haben kann. Vier Kinder werden laut Angaben von Donnerstag auf Intensivstationen behandelt, drei von ihnen mussten an eine Dialyse.
Für Menschen, die in Pflegeheimen leben und oft bereits gesundheitlich geschwächt sind, kann eine Infektion der Mitteilung zufolge sehr schwerwiegende Folgen haben. Aber auch Kinder sind besonders gefährdet, weil ihr Immunsystem und ihre Organe noch nicht ausgereift sind.